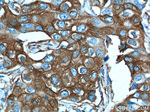
PADI4 Antibody in Immunohistochemistry (Paraffin) (IHC (P))
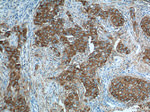
PADI4 Antibody in Immunohistochemistry (Paraffin) (IHC (P))

Search
Proteintech
PADI4 Polyclonal Antibody
{{$productOrderCtrl.translations['antibody.pdp.commerceCard.promotion.promotions']}}
{{$productOrderCtrl.translations['antibody.pdp.commerceCard.promotion.viewpromo']}}
{{$productOrderCtrl.translations['antibody.pdp.commerceCard.promotion.promocode']}}: {{promo.promoCode}} {{promo.promoTitle}} {{promo.promoDescription}}. {{$productOrderCtrl.translations['antibody.pdp.commerceCard.promotion.learnmore']}}
产品信息
17373-1-AP
种属反应
已发表种属
宿主/亚型
分类
类型
抗原
偶联物
形式
浓度
规格
纯化类型
保存液
内含物
保存条件
运输条件
产品详细信息
Immunogen sequence: EDFLKSVTT LAMKAKCKLT ICPEEENMDD QWMQDEMEIG YIQAPHKTLP VVFDSPRNRG LKEFPIKRVM GPDFGYVTRG PQTGGISGLD SFGNLEVSPP VTVRGKEYPL GRILFGDSCY PSNDSRQMHQ ALQDFLSAQQ VQAPVKLYSD WLSVGHVDEF LSFVPAPDRK GFRLLLASPR SCYKLFQEQQ NEGHGEALLF EGIKKKKQQK IKNILSNKTL REHNSFVERC IDWNRELLKR ELGLAESDII DIPQLFKLKE FSKAEAFFPN MVNMLVLGKH LGIPKPFGPV INGRCCLEEK VCSLLEPLGL QCTFINDFFT YHIRHGEVHC GTNVRRKPFS FKWWNMVP (317-663 aa encoded by BC025718)
靶标信息
Catalyzes the citrullination/deimination of arginine residues of proteins. Citrullinates histone H3 at 'Arg-8' and/or 'Arg-17' and histone H4 at 'Arg-3', which prevents their methylation by CARM1 and HRMT1L2/PRMT1 and represses transcription. Citrullinates EP300/P300 at 'Arg-2142', which favors its interaction with NCOA2/GRIP1.
仅用于科研。不用于诊断过程。未经明确授权不得转售。
生物信息学
蛋白别名: HL-60 PAD; PAD type IV; PAD-R4; PADI-H protein; peptidyl arginine deiminase, type 4; peptidyl arginine deiminase, type IV; peptidyl arginine deiminase, type V; Peptidylarginine deiminase IV; Peptidylarginine deiminase type alpha; Protein-arginine deiminase type IV; Protein-arginine deiminase type-4; unnamed protein product
基因别名: PAD; PAD4; PADI4; PADI5; PDI4; PDI5
UniProt ID: (Human) Q9UM07, (Rat) O88807, (Mouse) Q9Z183
Entrez Gene ID: (Human) 23569, (Rat) 29512, (Mouse) 18602